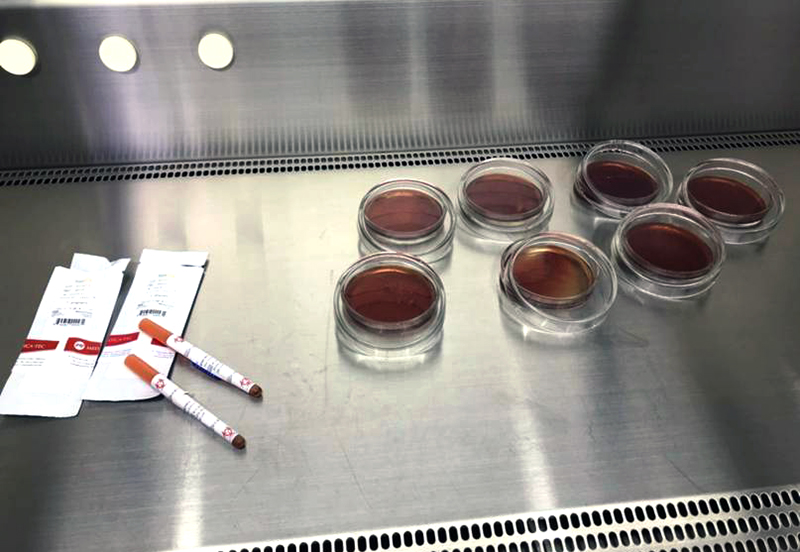
Estudio de la UNNE advierte sobre enfermedad periodontal en embarazadas y sus riesgos Estudio de la UNNE advierte sobre enfermedad periodontal en embarazadas y sus riesgos

Investigadores detectaron una alta frecuencia de bacterias asociadas a esta patología en gestantes de Corrientes. Alertan que puede provocar complicaciones obstétricas y remarcan la importancia del control odontológico durante el embarazo.
La enfermedad periodontal, un proceso inflamatorio crónico que afecta las encías, el ligamento periodontal y el hueso que sostiene los dientes, encendió las alertas en el ámbito científico tras un estudio realizado en mujeres embarazadas de la ciudad de Corrientes.
La investigación fue desarrollada por docentes e investigadores de la Facultad de Odontología de la Universidad Nacional del Nordeste (Unne), quienes detectaron una alta frecuencia de bacterias vinculadas a esta patología en gestantes.
Esta enfermedad se origina por la acumulación de biopelícula bacteriana sobre la superficie de los dientes, especialmente en el surco gingival, donde los microorganismos encuentran condiciones favorables para multiplicarse. Si no se diagnostica y trata a tiempo, puede provocar inflamación, sangrado y, en estadios avanzados, la pérdida de piezas dentarias.
Durante el embarazo, el impacto de la enfermedad periodontal no se limita a la salud bucodental. Según los especialistas, las bacterias pueden ingresar al torrente sanguíneo y, en determinadas circunstancias, afectar tanto a la madre como al bebé. Diversas investigaciones han asociado esta patología con complicaciones obstétricas como el parto prematuro, la preeclampsia y el bajo peso al nacer.
En este contexto, el equipo de la Unne llevó adelante un estudio en el Laboratorio de Investigaciones Científicas, Área Microbiología, con el objetivo de determinar la frecuencia de bacterias relacionadas con la enfermedad periodontal en embarazadas correntinas. Los resultados evidenciaron que una proporción significativa de las mujeres analizadas presentaba algún grado de la enfermedad, además de una elevada presencia de microorganismos vinculados a formas más severas.
Los hallazgos refuerzan la necesidad de promover la educación en salud bucal durante el embarazo, ya que muchas veces esta patología avanza sin síntomas evidentes en sus etapas iniciales. La detección temprana y el tratamiento oportuno son claves para prevenir complicaciones mayores.
Los especialistas recomendaron adoptar hábitos de higiene adecuados, como el cepillado correcto de los dientes, el uso diario de hilo dental y la realización de controles odontológicos periódicos. Estas medidas simples resultan fundamentales para prevenir la acumulación de bacterias y proteger la salud bucal.
Asimismo, remarcaron la importancia del trabajo interdisciplinario entre odontólogos, obstetras y otros profesionales de la salud, con el fin de brindar un abordaje integral a las mujeres embarazadas. La articulación entre distintas áreas permite detectar factores de riesgo y actuar de manera preventiva.
Desde el ámbito académico, concluyeron que el cuidado de la salud bucal debe formar parte de los controles prenatales habituales. La prevención y el seguimiento profesional no solo contribuyen al bienestar de la madre, sino que también representan un factor clave para garantizar el desarrollo saludable del bebé.
El Litoral